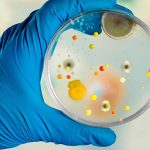
super-saudavel-materia-da-edicao-novidade-para-detectar-patogenos Bactérias resistentes a antibióticos

A dermatite atópica demanda cuidado multidisciplinar

Como o microbioma interfere na dermatite atópica

Herpes zoster tem quadros de dor intensa
Novidade para detectar patógenos

As novas diretrizes para hipertensão arterial

Detecção e isolamento do LcS nas fezes humanas

Placenta ganha novos papéis na medicina

Os muitos benefícios das frutas brasileiras

O poder da imposição de mãos

Fruticasa recebe certificação internacional